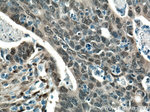
YAP1 Antibody in Immunohistochemistry (Paraffin) (IHC (P))

Search
Proteintech
YAP1 Polyclonal Antibody
{{$productOrderCtrl.translations['antibody.pdp.commerceCard.promotion.promotions']}}
{{$productOrderCtrl.translations['antibody.pdp.commerceCard.promotion.viewpromo']}}
{{$productOrderCtrl.translations['antibody.pdp.commerceCard.promotion.promocode']}}: {{promo.promoCode}} {{promo.promoTitle}} {{promo.promoDescription}}. {{$productOrderCtrl.translations['antibody.pdp.commerceCard.promotion.learnmore']}}
产品信息
13584-1-AP
种属反应
已发表种属
宿主/亚型
分类
类型
抗原
偶联物
形式
浓度
规格
纯化类型
保存液
内含物
保存条件
运输条件
产品详细信息
This antibody is a rabbit polyclonal antibody. The calculated molecular weight of YAP1 is 54 kDa, but phosphorylated YAP1 is about 65 kDa.
Immunogen sequence: PTAQHLRQS SFEIPDDVPL PAGWEMAKTS SGQRYFLNHI DQTTTWQDPR KAMLSQMNVT APTSPPVQQN MMNSASGPLP DGWEQAMTQD GEIYYINHKN KTTSWLDPRL DPRFAMNQRI SQSAPVKQPP PLAPQSPQGG VMGGSNSNQQ QQMRLQQLQM EKERLRLKQQ ELLRQAMRNI NPSTANSPKC QELALRSQLP TLEQDGGTQN PVSSPGMSQE LRTMTTNSSD PFLNSGTYHS RDESTDSGLS MSSYSVPRTP DDFLNSVDEM DTGDTINQST LPSQQNRFPD YLEAIPGTNV DLGTLEGDGM NIEGEELMPS LQEALSSDIL NDMESVLAAT KLDKESFLTW L (155-504 aa encoded by BC038235)
靶标信息
YAP (Yes-Associated Protein) is a founding member of the WW domain family of proteins, transcriptional co-activator and oncogene. Its gene is transcriptionally activated in squamous cell carcinoma cells. YAP can act both as a coactivator and corepressor and is the critical downstream regulatory target in the Hippo signaling pathway. The Hippo signaling pathway plays a pivotal role in organ size control and tumour suppression by restricting proliferation and promoting apoptosis. Also plays key roles in tissue tension, 3D tissue shape, cell proliferation, cell death, and cell migration. Mutations in the IRF5 gene results in coloboma.
仅用于科研。不用于诊断过程。未经明确授权不得转售。
生物信息学
蛋白别名: 65 kDa Yes-associated protein; Protein yorkie homolog; transcriptional co-activator; Transcriptional coactivator YAP1; unnamed protein product; Yes associated protein 1; Yes-associated protein 1; yes-associated protein 2; Yes-associated protein YAP65 homolog; yorkie homolog
基因别名: COB1; YAP; YAP-1; YAP1; YAP2; YAP65; YKI
UniProt ID: (Human) P46937
Entrez Gene ID: (Human) 10413